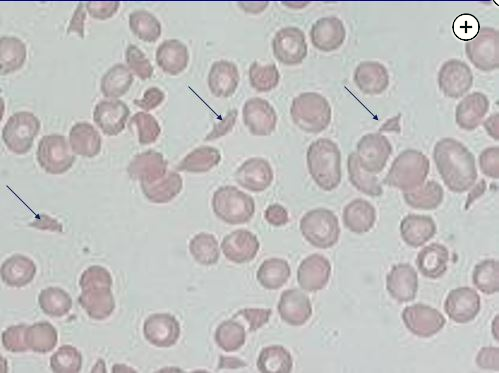

TTP thrombotic thrombocytopic purpura
- related: Hematology
- tags: #literature #hemeonc
This patient likely has thrombotic thrombocytopenic purpura (TTP), which is characterized by the formation of small-vessel, platelet-rich thrombi due to severe deficiency of the von Willebrand factor–cleaving protein ADAMTS13. TTP can be associated with pregnancy due to the formation of autoantibodies (acquired) or the emergence of a previously unknown heredity case.
Pathogenesis
- ADAMTS13 cleaves VWF on endothelial cell and prevents platelet clotting
- ADAMTS13 antibody prevents above process, inactivates or destroys platelets Acquired TTP is a primary TMA syndrome due to severely decreased ADAMTS13 activity (usually <10%) and is caused by autoantibodies against the von Willebrand (VW) factor-cleaving protease, ADAMTS13. This allows unchecked adhesion of VW factor multimers to platelets and microthromboses. The end result is thrombocytopenia, MAHA, and organ ischemia. It is considered a medical emergency with a high mortality rate if not recognized and treated. TTP is a rare condition developing in about three in one million adults annually.
Symptoms, Diagnosis, Scoring
Treatment
TMAs are defined by a pathologic lesion in arterioles and capillaries resulting in microvascular thrombosis and have the findings of microangiopathic hemolytic anemia (MAHA), schistocytes seen on peripheral blood smear (Figure 3, arrows), and thrombocytopenia. There are several different TMAs. Primary TMAs include classic acquired thrombocytopenic purpura (TTP), which can be immune or hereditary and is due to severe ADAMTS13 deficiency; hemolytic uremic syndrome from Shiga toxin; complement-mediated TMA, which can be acquired or hereditary; drug-induced TMA; or metabolism or coagulation-mediated TMA. Other causes of MAHA and thrombocytopenia include disseminated intravascular coagulation, infection, some malignancies, pregnancy-related disorders such as preeclampsia or HELLP syndrome, severe hypertension, and collagen vascular disease and after organ and hematopoietic cell transplant.
Wright-Giemsa stain magnified 100x.
Wright-Giemsa stain magnified 100x.